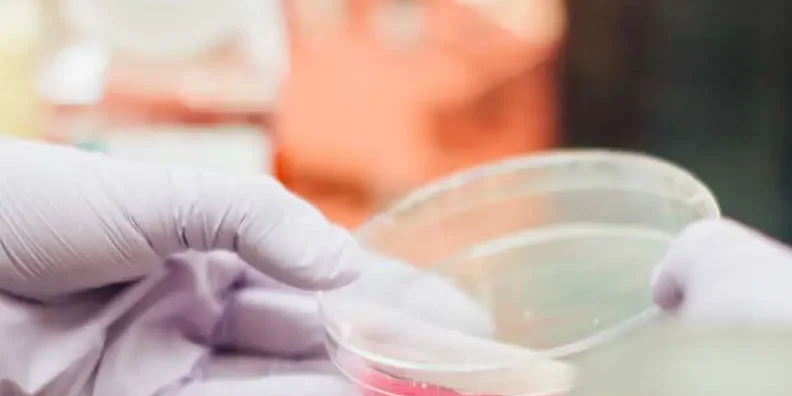

Aujourd’hui, intégrer l’IA dans sa stratégie marketing est incontournable pour rester compétitif. L’intelligence artificielle redéfinit les méthodes de segmentation des audiences, personnalise les parcours clients, et automatise des processus critiques tels que l’analyse de données et la création de contenu.